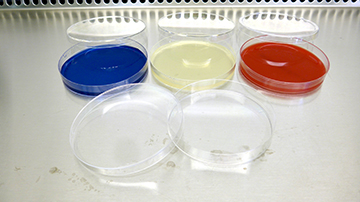

2025年12月5日
歯学研究演習
必須授業の歯学研究演習の講義が終わり,完全選択制の歯学研究演習の課外実験が始まります.

当分野には,受入れ上限数の学生から課外実験の申込みがありました.
最初に各学生の希望をヒアリングし,それぞれに適したプログラムを提示します.
2025年12月4日
初雪
新潟市内に,今冬はじめての降雪がありました.

積雪はありませんでしたが,転倒等に注意し建物間を移動します.
2025年12月3日
研究報告会
2025年最後のデータミーティングと実験ノート確認を実施しました.

ミーティング内容も踏まえ,年末までの実験計画を再確認します.
2025年12月2日
実験法令のe-Learning
各種規則に基づき,実験法令のオンライン講習と小テストを受験しました.

引き続き,規則・法令の遵守に務めます.
2025年11月28日
塩尻にて
教育と研究の両面で連携中の松本歯科大学を訪問中です.

授業では,毎回のことながら素晴らしい受講態度に感銘を受けます.

2025年11月26日
情報セキュリティ講習2025
学内規則に従い,「情報セキュリティ講習2025」を受講しました.

確認試験にも合格し,バッジを獲得しました.講習内容を踏まえ,セキュリティの確保に務めます.
2025年11月20日
実験と論文の進捗報告
投稿中の論文査読の進捗と実験データの報告会を実施しました.質疑や討論を行いつつ,次実験の内容と購入試薬を決定します.

出荷調整の製品もあるため,直ちに必要試薬の確保に取り掛かります.
2025年11月19日
教科書の新版へ
医学科の教科書は,新版の刊行となります.

次なる学修を期して,分担箇所を執筆します.
2025年11月18日
教科書の改訂中
感染症を取り巻く情勢や予防・治療方法は,毎年アップデートしています.

最新かつ正確な学修を期すため,歯学科と口腔生命福祉学科で使う教科書のそれぞれを毎年改訂しています.
2025年11月14日
免疫学の開講
来週木曜から,「免疫学」授業が始まります.教科書は,現在の「ウイルス学」と共通です.

ノーベル賞の受賞対象となった“Treg”についても,興味を持って学んでください.
2025年11月12日
研究報告と論文抄読会
今朝は院生さん2名が担当となり,それぞれ研究報告と論文紹介を実施しました.

紹介論文から研究報告の実験にフィードバックされる情報もあり,有意義な時間となりました.
2025年11月10日
新潟歯学会:令和7年度第2回
先週末に,令和7年度新潟歯学会第2回例会が開催されました.

院生さん達の学位研究を中心とした発表と質疑が行われました.
